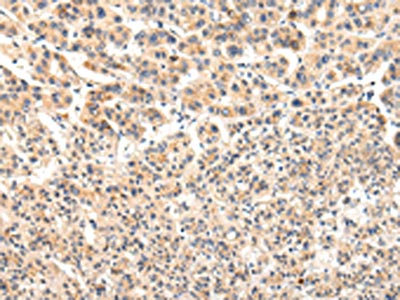

-
中文名稱:VPS33A兔多克隆抗體
-
貨號:CSB-PA128038
-
規格:¥1100
-
圖片:
-
The image on the left is immunohistochemistry of paraffin-embedded Human thyroid cancer tissue using CSB-PA128038(VPS33A Antibody) at dilution 1/30, on the right is treated with fusion protein. (Original magnification: ×200)
-
The image on the left is immunohistochemistry of paraffin-embedded Human liver cancer tissue using CSB-PA128038(VPS33A Antibody) at dilution 1/30, on the right is treated with fusion protein. (Original magnification: ×200)
-
-
其他:
產品詳情
-
Uniprot No.:
-
基因名:VPS33A
-
別名:VPS33AVacuolar protein sorting-associated protein 33A antibody; hVPS33A antibody
-
宿主:Rabbit
-
反應種屬:Human,Mouse,Rat
-
免疫原:Fusion protein of Human VPS33A
-
免疫原種屬:Homo sapiens (Human)
-
標記方式:Non-conjugated
-
抗體亞型:IgG
-
純化方式:Antigen affinity purification
-
濃度:It differs from different batches. Please contact us to confirm it.
-
保存緩沖液:-20°C, pH7.4 PBS, 0.05% NaN3, 40% Glycerol
-
產品提供形式:Liquid
-
應用范圍:ELISA,IHC
-
推薦稀釋比:
Application Recommended Dilution ELISA 1:2000-1:5000 IHC 1:25-1:100 -
Protocols:
-
儲存條件:Upon receipt, store at -20°C or -80°C. Avoid repeated freeze.
-
貨期:Basically, we can dispatch the products out in 1-3 working days after receiving your orders. Delivery time maybe differs from different purchasing way or location, please kindly consult your local distributors for specific delivery time.
-
用途:For Research Use Only. Not for use in diagnostic or therapeutic procedures.
相關產品
靶點詳情
-
功能:Plays a role in vesicle-mediated protein trafficking to lysosomal compartments including the endocytic membrane transport and autophagic pathways. Believed to act as a core component of the putative HOPS and CORVET endosomal tethering complexes which are proposed to be involved in the Rab5-to-Rab7 endosome conversion probably implicating MON1A/B, and via binding SNAREs and SNARE complexes to mediate tethering and docking events during SNARE-mediated membrane fusion. The HOPS complex is proposed to be recruited to Rab7 on the late endosomal membrane and to regulate late endocytic, phagocytic and autophagic traffic towards lysosomes. The CORVET complex is proposed to function as a Rab5 effector to mediate early endosome fusion probably in specific endosome subpopulations. Required for fusion of endosomes and autophagosomes with lysosomes; the function is dependent on its association with VPS16 but not VIPAS39. The function in autophagosome-lysosome fusion implicates STX17 but not UVRAG.
-
基因功能參考文獻:
- Mutations in VPS33A is associated with mucopolysaccharidosis with severe systemic symptoms. PMID: 28013294
- The clinical phenotype and genetic studies support the suggestion that the siblings most probably have a novel disease very likely caused by a VPS33A gene defect. PMID: 27547915
- association of VPS33A with HOPS via its interaction with VPS16 is required for both endosome- and autophagosome-lysosome fusion PMID: 25783203
- Melanoma cells depleted of vacuolar protein sorting 33A protein have increased nuclear localization of cis-diaminedichloroplatinum II, increased nuclear DNA damage by platination, and increased apoptosis, resulting in increased treatment sensitivity. PMID: 22203954
- VPS33A is mutated in Hermansky-Pudlak syndrome and may have a role in melanogenesis PMID: 12538872
- A and B classes reflect the evolution of organelle/tissue-specific functions PMID: 15790593
顯示更多
收起更多
-
相關疾病:Mucopolysaccharidosis-plus syndrome (MPSPS)
-
亞細胞定位:Cytoplasmic vesicle. Late endosome membrane; Peripheral membrane protein; Cytoplasmic side. Lysosome membrane; Peripheral membrane protein; Cytoplasmic side. Early endosome. Cytoplasmic vesicle, autophagosome. Cytoplasmic vesicle, clathrin-coated vesicle.
-
蛋白家族:STXBP/unc-18/SEC1 family
-
數據庫鏈接:
Most popular with customers
-
-
Phospho-YAP1 (S127) Recombinant Monoclonal Antibody
Applications: ELISA, WB, IHC
Species Reactivity: Human
-
-
-
-
-
-